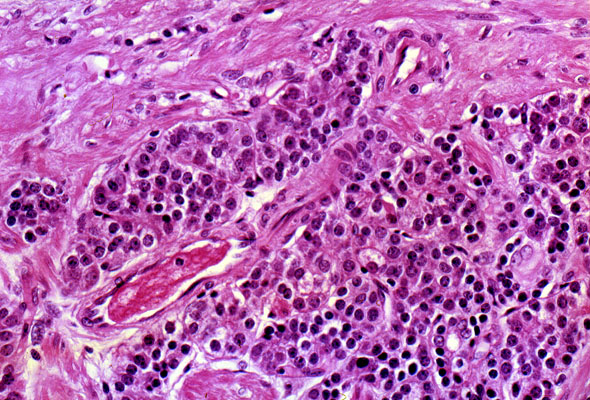

Carcinoid of the appendix, histology, higher magnification
Click picture to enlarge. Close window to return
The tumor is composed of a uniform population of cells that have regular round nuclei and moderate amount of cytoplasm. The tumor cells are arranged into broad sheets and do not form glands or other recognizable structures.